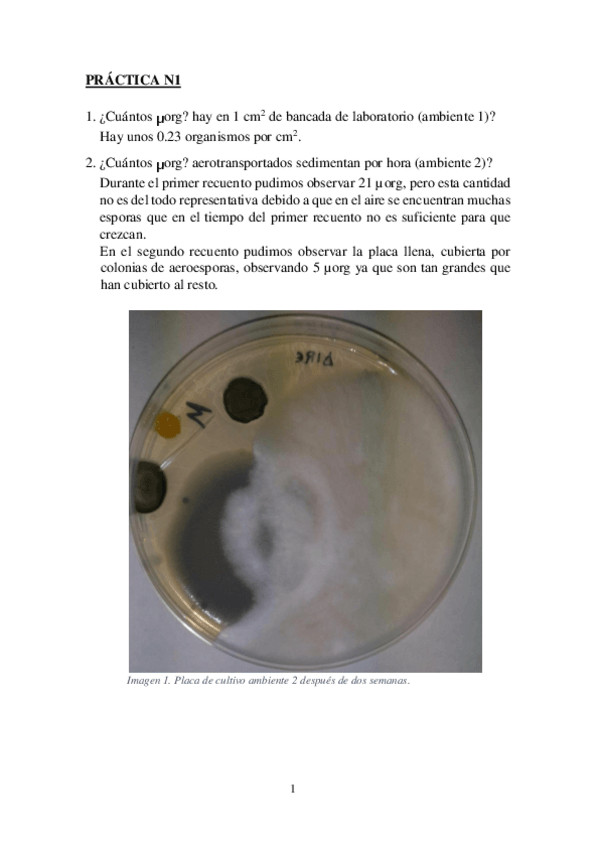

@Enrique111114
85 Publicaciones
2.99k Interacciones
1 Seguidores
0 Siguiendo
Lista de publicaciones de Enrique111114
apuntes
-
Apuntes completos EIA
He publicado nuevos apuntes de 3º Evaluación de Impacto Ambiental: Apuntes completos EIA
apuntes
-
Apuntes completos EGP
He publicado nuevos apuntes de 3º Elaboración y Gestión de Proyectos: Apuntes completos EGP
practicas
-
Lecturas completas
He publicado nuevos practicas de 2º Geografía Física: Lecturas completas
apuntes
-
Apuntes Geografia Física completos
He publicado nuevos apuntes de 2º Geografía Física: Apuntes Geografia Física completos
apuntes
-
Apuntes completos ECA
He publicado nuevos apuntes de 2º Evaluación de la Contaminación Ambiental: Apuntes completos ECA
He publicado nuevos apuntes de 2º Ecología: Apuntes Ecologia completos.pdf
He publicado nuevos practicas de 2º Microbiología Ambiental: Practicas microbiologia ambiental.pdf
He publicado nuevos ejercicios de 2º Evaluación de la Contaminación Ambiental: Problemas propuestos 1.pdf
He publicado nuevos practicas de 2º Hidrología Continental y Marina: Practicas hidrologia + Fenomeno del Niño.pdf
He publicado nuevos practicas de 2º Hidrología Continental y Marina: Ejercicio_1-Recursos hídricos.pdf
He publicado nuevos trabajos de 2º Evaluación de la Contaminación Ambiental: Practica informatica.pdf